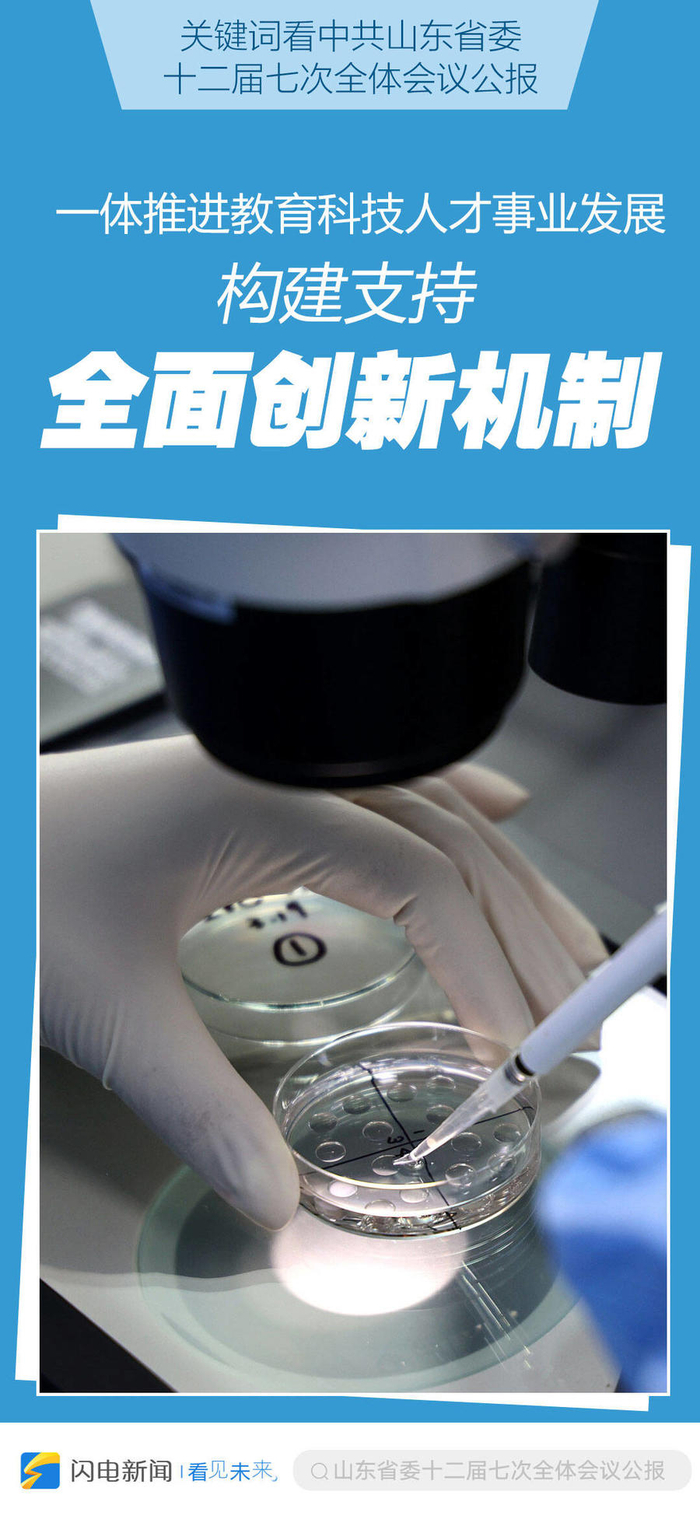

转自:山东要闻

(闪电新闻)


